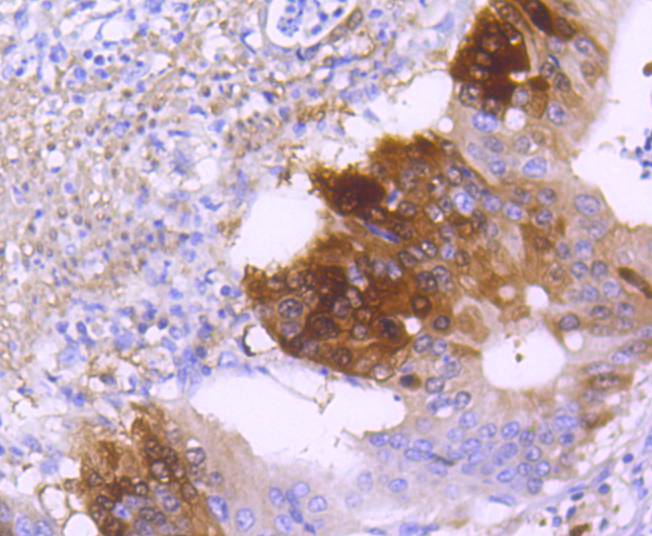
产品细节图片4

相关产品推荐更多 >
万千商家帮你免费找货
0 人在求购买到急需产品
- 详细信息
- 文献和实验
- 技术资料
- 免疫原:
recombinant protein
- 形态:
liquid
- 保存条件:
Store at -20˚C
- 克隆性:
Monoclonal antibody
- 适应物种:
Human;Mouse;Rat
- 保质期:
12 months
- 抗原来源:
Recombinant Rabbit
- 供应商:
南京赛戈巍生物科技有限公司
- 宿主:
Recombinant Rabbit
- 应用范围:
WB, ICC/IF, IHC, IP, FC
- 靶点:
Uniprot:Q9UD71
- 抗体英文名:
DARPP32 Rabbit mAb
- 规格:
50ul/100ul
DARPP-32 antibody
Dopamine and cAMP regulated neuronal phosphoprotein 32 antibody
Dopamine and cAMP regulated neuronal phosphoprotein antibody
Dopamine and cAMP regulated phosphoprotein antibody
Dopamine and cAMP regulated phosphoprotein DARPP 32 antibody
Dopamine and cAMP regulated phosphoprotein DARPP32 antibody
Dopamine- and cAMP-regulated neuronal phosphoprotein antibody
FLJ20940 antibody
IPPD antibody
Neuronal phosphoprotein DARPP 32 antibody
PPP1R1B antibody
PPR1B_HUMAN antibody
Protein phosphatase 1 regulatory (inhibitor) subunit 1B antibody
Protein phosphatase 1 regulatory inhibitor subunit 1B antibody
Protein phosphatase 1 regulatory subunit 1B antibody
计算分子量:32 kDa
配方:1*TBS (pH7.4), 1%BSA, 40%Glycerol. Preservative: 0.05% Sodium Azide.
应用详情:WB: 1:1,000-5,000
IHC: 1:50-1:200
ICC: 1:50-1:200
FC: 1:50-1:100
图片:

Western blot analysis of DARPP32 on mouse brain lysates using anti-DARPP32 antibody at 1/1,000 dilution.
,

Immunohistochemical analysis of paraffin-embedded rat brain tissue using anti-DARPP32 antibody. Counter stained with hematoxylin.
,

Immunohistochemical analysis of paraffin-embedded human breast carcinoma tissue using anti-DARPP32 antibody. Counter stained with hematoxylin.
,
Immunohistochemical analysis of paraffin-embedded human gastric carcinoma tissue using anti-DARPP32 antibody. Counter stained with hematoxylin.
,

ICC staining DARPP32 in SH-SY-5Y cells (green). The nuclear counter stain is DAPI (blue). Cells were fixed in paraformaldehyde, permeabilised with 0.25% Triton X100/PBS.
,

ICC staining DARPP32 in MCF-7 cells (green). The nuclear counter stain is DAPI (blue). Cells were fixed in paraformaldehyde, permeabilised with 0.25% Triton X100/PBS.
,

Flow cytometric analysis of Hela cells with DARPP32 antibody at 1/50 dilution (red) compared with an unlabelled control (cells without incubation with primary antibody; black). Alexa Fluor 488-conjugated goat anti rabbit IgG was used as the secondary antibody.
风险提示:丁香通仅作为第三方平台,为商家信息发布提供平台空间。用户咨询产品时请注意保护个人信息及财产安全,合理判断,谨慎选购商品,商家和用户对交易行为负责。对于医疗器械类产品,请先查证核实企业经营资质和医疗器械产品注册证情况。
文献和实验:使用 Anti-phospho-Akt (Ser473) Rabbit mAb 对石蜡包埋的人乳腺癌组织进行免疫组织化学分析。(图 A)使用免疫组化试剂盒M&R HRP/DAB Detection IHC Kit,抗体 1:100 稀释;(图 B) 采用普通免疫组化试剂盒,抗体 1:25 稀释。 图 6 免疫组化实验检测 Erk1/2 表达 注:使用 Anti-Erk1/2 Mouse mAb与p44/42 MAPK (Erk1/2)Rabbit mAb 对正常小鼠心脏组织进行免疫
h)即可。2. 修复大法——不仅仅是「煮一煮」微波炉修复:简单易行效果好,CST 推荐使用微波炉完成修复。合适的修复液:根据抗体说明书使用合适的修复液。用柠檬酸修复后,切片需浸泡在修复液中,自然冷却;而用 EDTA 修复后,切片可直接从修复缸中取出,直接进行下一步。注:使用不同的修复方式和不同生产商的抗体检测人肺癌组织中 EGFR 的表达。第一排为 CST 的 EGF Receptor (D38B1) XP® Rabbit mAb(#4267),EDTA 的修复方式明显优于柠檬酸盐及胃蛋白
到 PVDF 膜上,同时减少蛋白不必要降解,这对于最终获得清晰、可信结果也是需要考虑因素。抗体信息:1.ACC1, Recombinant Rabbit monoclonal IgG. HuaAn. HuaAn biotechnology , inc.2.ATGL, Mouse mAb IgG1, Cat#:RT1058. HuaAn biotechnology , inc.3.p-PERK(Thr981), Rabbit Polyclonal IgG primary antibodies, Cat
技术资料暂无技术资料 索取技术资料





![POLR1E Antibody[47299]](https://img1.dxycdn.com/p/s14/2025/0923/496/0462304380155040791.jpg!wh200)
![BMP6 Conjugated Antibody[C56493]](https://img1.dxycdn.com/p/s14/2025/0922/632/2321321568067599691.jpg!wh200)
![KPB1/2 Antibody[33776]](https://img1.dxycdn.com/p/s14/2025/0922/359/6146153295428599691.jpg!wh200)
